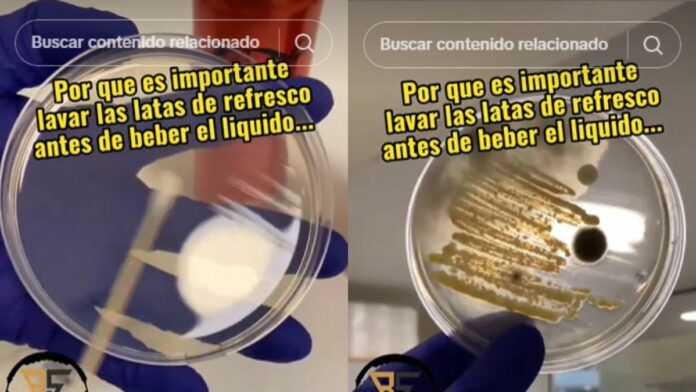

Gracias a una cuenta de TikTok que realizó un experimento hemos podido conocer todas las bacterias que pueden existir en una lata de refresco que, casi siempre consumimos sin limpiar.
En el video compartido, se muestra a una persona que toma una lata de refresco y la somete a un sencillo análisis a través de la incubación de las muestras.
El análisis constó de cuatro pruebas; una muestra sin limpiar la lata, otro con la lata limpiada únicamente con la ropa, una más de la lata limpiada con una servilleta y finalmente una muestra de la lata desinfectada con alcohol.
El hombre pasó un hisopo por la parte superior de la lata para posteriormente deslizarlo en una placa de Petri para poder llevar a cabo la prueba de cultivo y así detectar la presencia de bacterias y organismos diminutos.
@puchinis79 #latasderefresco #higiene #viral #viralvideo #bacterias ♬ Mysterious – Andreas Scherren
Los resultados de la prueba de la ropa mostró rastros de bacterias y hongos, pero en poca cantidad. Mientras que las pruebas que fueron limpiadas con una servilleta y la otra con alcohol los resultados no detectaron microorganismos peligrosos.
Gracias a este video viral y a la prueba realizada por este hombre, podemos tomar medidas de limpieza adecuadas antes de tomar refresco directo de la lata.
Por Redacción
Editor: Daniel Martínez
Te recomendamos